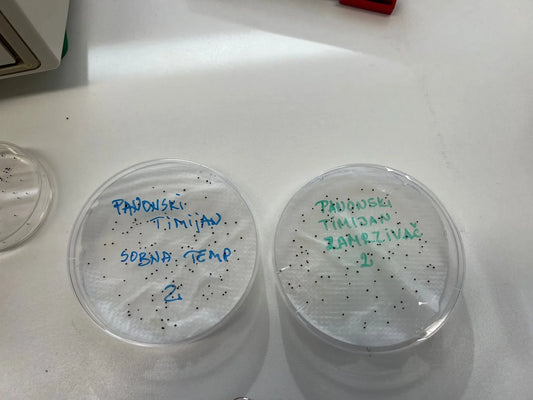

Meli Nauka
Saradnja sa Farmaceutskim Fakultetom
Saradnja sa Farmaceutskim fakuletetom i profesorom Zoranom Maksimovićem na ispitivanju svojstava i delovanja različitih proizvoda citralalnog fenotipa panonskog timijana.
Saradnja sa Farmaceutskim Fakultetom
Saradnja sa Farmaceutskim fakuletetom i profesorom Zoranom Maksimovićem na ispitivanju svojstava i delovanja različitih proizvoda citralalnog fenotipa panonskog timijana.